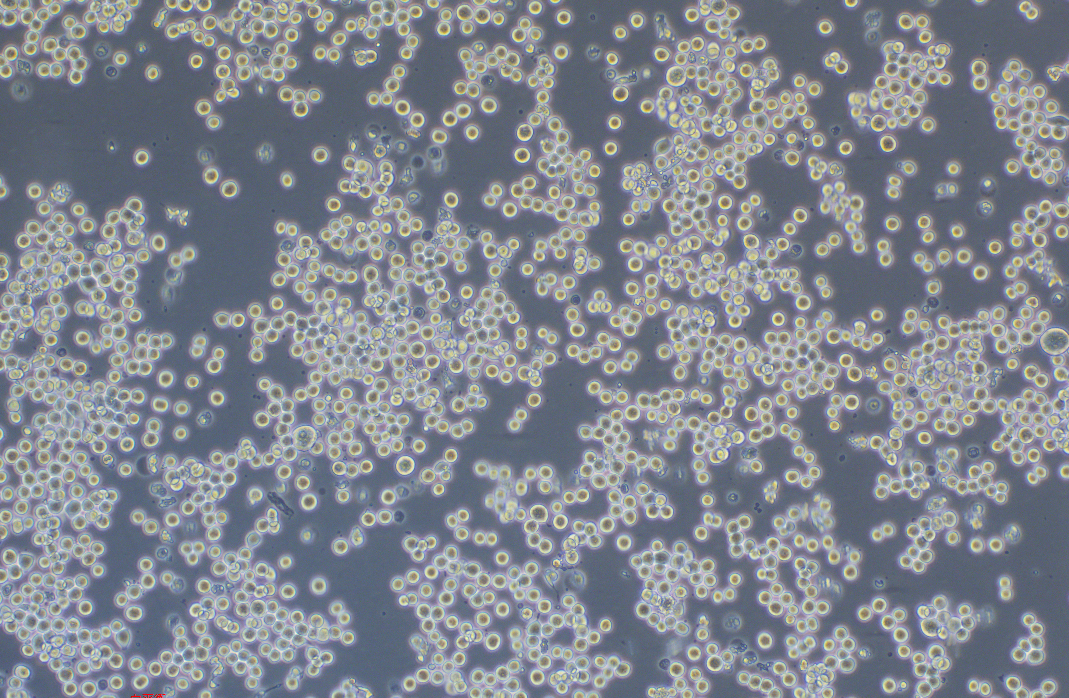

|
種屬 |
人 |
|
別稱 |
Colo 205; CoLo 205; COLO-205; Colo-205; COLO.205; Colo205; COLO205; Co 205; Colorado 205 |
|
組織來源 |
源自轉移部位:腹水 |
|
疾病 |
結腸腺癌 |
|
傳代比例/細胞消化 |
1:2傳代,懸浮部分離心收集(1000RPM,5分鐘),貼壁部分消化2-3分鐘 |
|
完全培養基配置 |
RPMI1640培養基;10%胎牛血清; 1%雙抗 |
|
簡介 |
該細胞系是1957年由T.U.SAMPLE等從患有結腸癌的70歲男性白人的腹水中分離的。 該病人在取腹水樣品前已用5-氟尿嘧啶治療4~6周。角蛋白免疫過氧化物酶染色陽性;產生CEA、IL10 |
|
形態 |
上皮細胞樣 |
|
生長特征 |
貼壁,懸浮混合生長 |
|
倍增時間 |
~25-30h |
|
基因表達 |
carcinoembryonic antigen (CEA) 1.5 to 4.1 ng/10^6 cells cells/10 days; keratin; interleukin 10 (IL-10, interleukin-10), The cells are positive for keratin by immunoperoxidase staining. |
|
致瘤性 |
Yes, in nude mice (Tumors developed within 21 days at 100% frequency (5/5) in nude mice inoculated subcutaneously with 1×10^7 cells). |
|
STR |
Amelogenin: X CSF1PO: 11,12 D13S317: 10,12 D16S539: 12,13 D5S818: 10,13 D7S820: 9,10 THO1: 8,9 TPOX: 11 vWA: 15 |
|
培養條件 |
氣相:空氣,95%;二氧化碳,5%。 溫度:37攝氏度,培養箱濕度為70%-80%。 |
|
凍存條件 |
凍存液:90%FBS,DMSO 10%, 或使用非程序凍存液:官網貨號JY-H040 |
|
保藏機構 |
ATCC; CCL-222 |
|
備注 |
該細胞為半懸浮和半貼壁細胞,懸浮細胞離心收集,貼壁細胞消化處理 |
|
產品使用 |
僅限于科學研究,不可作為動物或人類疾病的治療產品使用。 |